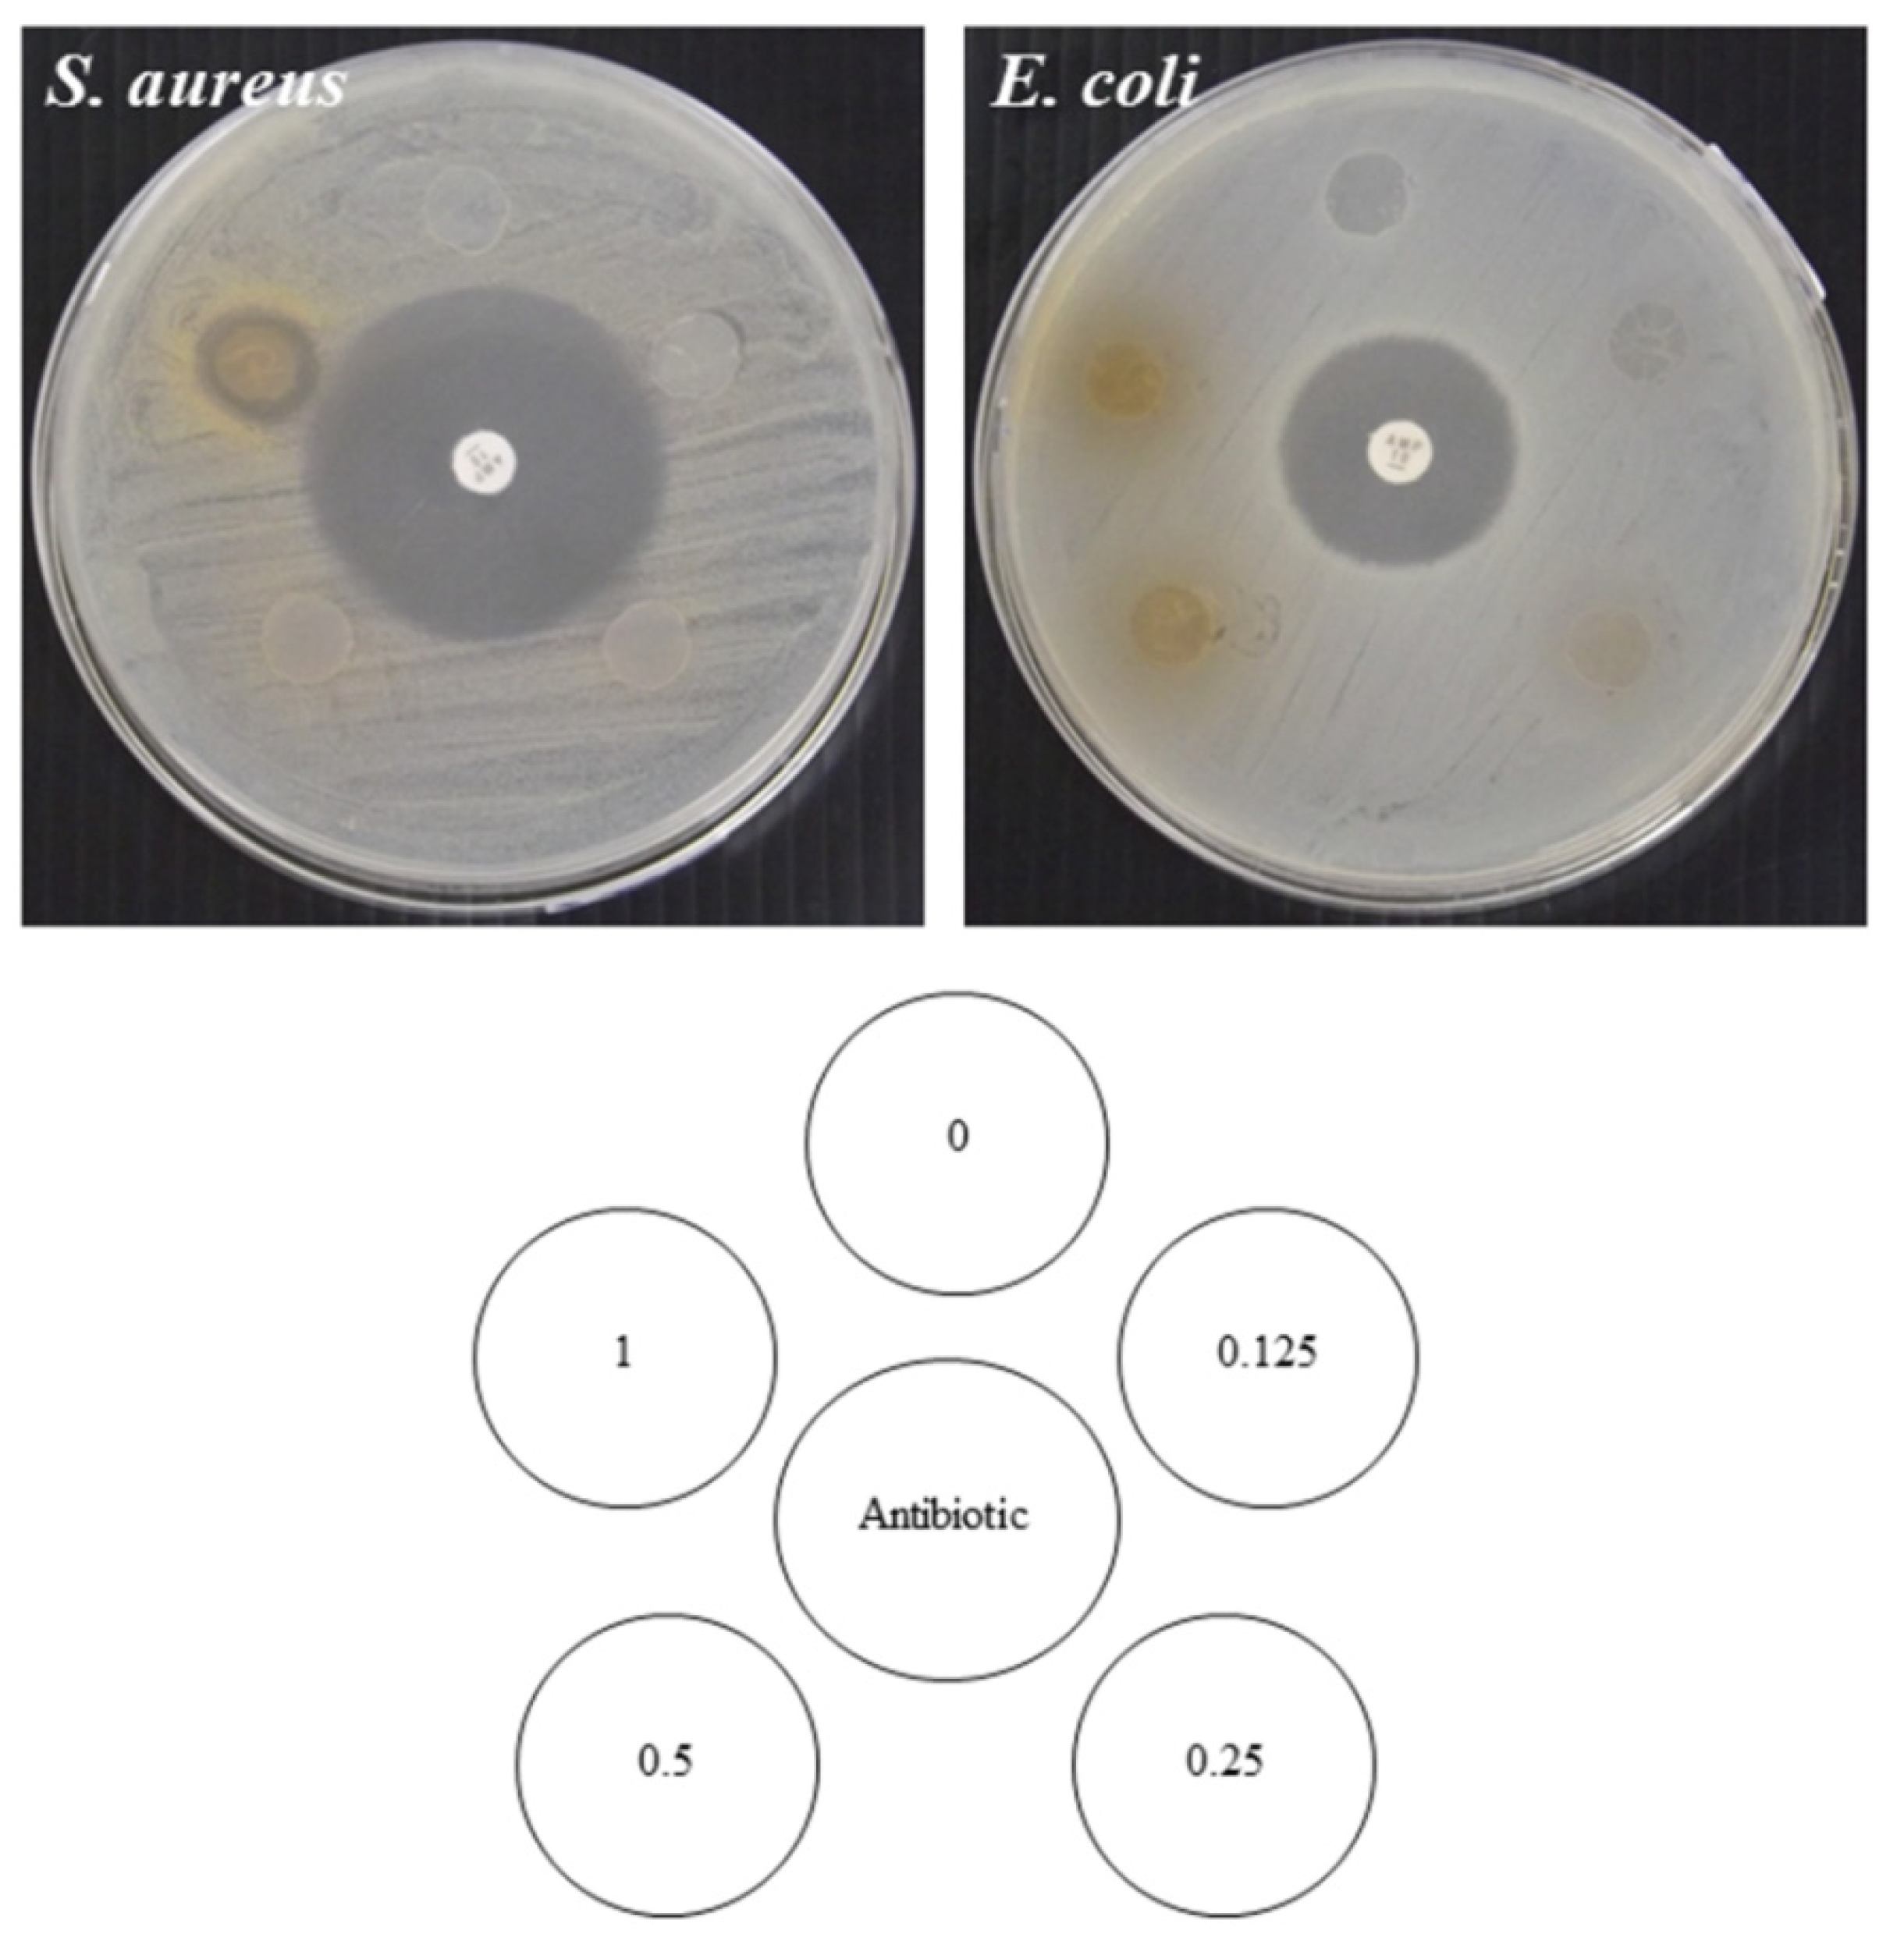
Polymers 14 02696 g004

Green Tea Extract Enrichment: Mechanical and Physicochemical Properties Improvement of Rice Starch-Pectin Composite Film
Abstract
:1. Introduction
2. Materials and Methods
2.1. Materials
2.2. Preparation of Green Tea Extract
2.3. Preparation of the RS-P Composite Film
2.4. Film Property Determination
2.4.1. Film Thickness
2.4.2. Film Appearance and Color
2.4.3. Film Transmittance and Transparency
2.4.4. Film Moisture Content and Solubility
2.4.5. Mechanical Properties
2.4.6. Water Vapor Permeability
2.4.7. Fourier Transform Infrared Spectroscopy Analysis
2.4.8. Determination of Total Phenolic Content
2.4.9. Determination of DPPH Radical Scavenging Activity
2.4.10. Determination of Ferric Reducing Antioxidant Power
2.4.11. Antimicrobial Activities Test
2.5. Statistical Analysis
3. Results
3.1. Film Appearance, Color, Transmittance, and Transparency
3.2. Film Thickness and Mechanical Property
3.3. Film Moisture Content and Film Solubility
3.4. Water Vapor Permeability
3.5. FTIR
3.6. Determination of Total Phenolic Content
3.7. Antioxidant Activities
3.8. Antimicrobial Activity
4. Conclusions
Author Contributions
Funding
Institutional Review Board Statement
Informed Consent Statement
Data Availability Statement
Acknowledgments
Conflicts of Interest
References
- Zinoviadou, K.G.; Kastanas, P.; Gougouli, M.; Biliaderis, C.G. Chapter 11—Innovative bio-based materials for packaging sustainability. In Innovation Strategies in the Food Industry, 2nd ed.; Galanakis, C.M., Ed.; Academic Press: Cambridge, MA, USA, 2022; pp. 173–192. [Google Scholar]
- Mathew, S.; Jayakumar, A.; Kumar, V.P.; Mathew, J.; Radhakrishnan, E.K. One-step synthesis of eco-friendly boiled rice starch blended polyvinyl alcohol bionanocomposite films decorated with in situ generated silver nanoparticles for food packaging purpose. Int. J. Biol. Macromol. 2019, 139, 475–485. [Google Scholar] [CrossRef] [PubMed]
- Pirsa, S.; Sani, I.K.; Mirtalebi, S.S. Nano-biocomposite based color sensors: Investigation of structure, function, and applications in intelligent food packaging. Food Packag. Shelf Life 2022, 31, 100789. [Google Scholar] [CrossRef]
- McKeen, L.W. 13—Renewable Resource, Sustainable and Biodegradable Polymers. In The Effect of UV Light and Weather on Plastics and Elastomers, 4th ed.; McKeen, L.W., Ed.; William Andrew Publishing: Norwich, NY, USA, 2019; pp. 425–438. [Google Scholar]
- Alves, V.D.; Costa, N.; Coelhoso, I.M. Barrier properties of biodegradable composite films based on kappa-carrageenan/pectin blends and mica flakes. Carbohydr. Polym. 2010, 79, 269–276. [Google Scholar] [CrossRef]
- Jayasekara, S.; Dissanayake, L.; Jayakody, L.N. Opportunities in the microbial valorization of sugar industrial organic waste to biodegradable smart food packaging materials. Int. J. Food Microbiol. 2022, 377, 109785. [Google Scholar] [CrossRef] [PubMed]
- Sady, S.; Błaszczyk, A.; Kozak, W.; Boryło, P.; Szindler, M. Quality assessment of innovative chitosan-based biopolymers for edible food packaging applications. Food Packag. Shelf Life 2021, 30, 100756. [Google Scholar] [CrossRef]
- Amin, U.; Khan, M.U.; Majeed, Y.; Rebezov, M.; Khayrullin, M.; Bobkova, E.; Shariati, M.A.; Chung, I.M.; Thiruvengadam, M. Potentials of polysaccharides, lipids and proteins in biodegradable food packaging applications. Int. J. Biol. Macromol. 2021, 183, 2184–2198. [Google Scholar] [CrossRef]
- Bajer, D.; Burkowska-But, A. Innovative and environmentally safe composites based on starch modified with dialdehyde starch, caffeine, or ascorbic acid for applications in the food packaging industry. Food Chem. 2022, 374, 131639. [Google Scholar] [CrossRef]
- Rai, S.K.; Chaturvedi, K.; Yadav, S.K. Evaluation of structural integrity and functionality of commercial pectin based edible films incorporated with corn flour, beetroot, orange peel, muesli and rice flour. Food Hydrocoll. 2019, 91, 127–135. [Google Scholar] [CrossRef]
- Chollakup, R.; Pongburoos, S.; Boonsong, W.; Khanoonkon, N.; Kongsin, K.; Sothornvit, R.; Sukyai, P.; Sukatta, U.; Harnkarnsujarit, N. Antioxidant and antibacterial activities of cassava starch and whey protein blend films containing rambutan peel extract and cinnamon oil for active packaging. LWT 2020, 130, 109573. [Google Scholar] [CrossRef]
- Domínguez, R.; Barba, F.J.; Gómez, B.; Putnik, P.; Kovačević, D.B.; Pateiro, M.; Santos, E.M.; Lorenzo, J.M. Active packaging films with natural antioxidants to be used in meat industry: A review. Food Res. Int. 2018, 113, 93–101. [Google Scholar] [CrossRef]
- Sarıcaoglu, F.T.; Turhan, S. Physicochemical, antioxidant and antimicrobial properties of mechanically deboned chicken meat protein films enriched with various essential oils. Food Packag. Shelf Life 2020, 25, 100527. [Google Scholar] [CrossRef]
- Erna, K.H.; Felicia, W.X.L.; Rovina, K.; Vonnie, J.M.; Huda, N. Development of curcumin/rice starch films for sensitive detection of hypoxanthine in chicken and fish meat. Carbohydr. Polym. Technol. Appl. 2022, 3, 100189. [Google Scholar] [CrossRef]
- Suriyatem, R.; Auras, R.A.; Rachtanapun, C.; Rachtanapun, P. Biodegradable Rice Starch/Carboxymethyl Chitosan Films with Added Propolis Extract for Potential Use as Active Food Packaging. Polymers 2018, 10, 954. [Google Scholar] [CrossRef] [PubMed] [Green Version]
- Tiozon, R.J.N.; Bonto, A.P.; Sreenivasulu, N. Enhancing the functional properties of rice starch through biopolymer blending for industrial applications: A review. Int. J. Biol. Macromol. 2021, 192, 100–117. [Google Scholar] [CrossRef]
- Bourtoom, T.; Chinnan, M.S. Preparation and properties of rice starch–chitosan blend biodegradable film. LWT-Food Sci. Technol. 2008, 41, 1633–1641. [Google Scholar] [CrossRef]
- Wittaya, T. Rice Starch-Based Biodegradable Films: Properties Enhancement. In Structure and Function of Food Engineering; InTechOpen: London, UK, 2012; Volume 5, pp. 103–134. [Google Scholar] [CrossRef]
- Thakur, R.; Pristijono, P.; Scarlett, C.J.; Bowyer, M.; Singh, S.P.; Vuong, Q.V. Starch-based films: Major factors affecting their properties. Int. J. Biol. Macromol. 2019, 132, 1079–1089. [Google Scholar] [CrossRef]
- Sornsumdaeng, K.; Seeharaj, P.; Prachayawarakorn, J. Property improvement of biodegradable citric acid-crosslinked rice starch films by calcium oxide. Int. J. Biol. Macromol. 2021, 193, 748–757. [Google Scholar] [CrossRef]
- Hasan, M.; Gopakumar, D.A.; Olaiya, N.; Zarlaida, F.; Alfian, A.; Aprinasari, C.; Alfatah, T.; Rizal, S.; Khalil, H.A. Evaluation of the thermomechanical properties and biodegradation of brown rice starch-based chitosan biodegradable composite films. Int. J. Biol. Macromol. 2020, 156, 896–905. [Google Scholar] [CrossRef]
- Farris, S.; Schaich, K.M.; Liu, L.; Cooke, P.H.; Piergiovanni, L.; Yam, K.L. Gelatin–pectin composite films from polyion-complex hydrogels. Food Hydrocoll. 2011, 25, 61–70. [Google Scholar] [CrossRef] [Green Version]
- Mellinas, C.; Ramos, M.; Jiménez, A.; Garrigós, M.C. Recent Trends in the Use of Pectin from Agro-Waste Residues as a Natural-Based Biopolymer for Food Packaging Applications. Materials 2020, 13, 673. [Google Scholar] [CrossRef] [Green Version]
- Qin, C.; Yang, G.; Zhu, C.; Wei, M. Characterization of edible film fabricated with HG-type hawthorn pectin gained using different extraction methods. Carbohydr. Polym. 2022, 285, 119270. [Google Scholar] [CrossRef] [PubMed]
- Pawar, R.; Jadhav, W.; Bhusare, S.; Borade, R.; Farber, S.; Itzkowitz, D.; Domb, A. Polysaccharides as carriers of bioactive agents for medical applications. In Natural-Based Polymers for Biomedical Applications; Elsevier: Amsterdam, The Netherlands, 2008; pp. 3–53. [Google Scholar]
- Chaichi, M.; Hashemi, M.; Badii, F.; Mohammadi, A. Preparation and characterization of a novel bionanocomposite edible film based on pectin and crystalline nanocellulose. Carbohydr. Polym. 2017, 157, 167–175. [Google Scholar] [CrossRef] [PubMed]
- Lin, D.; Zheng, Y.; Wang, X.; Huang, Y.; Ni, L.; Chen, X.; Wu, Z.; Huang, C.; Yi, Q.; Li, J.; et al. Study on physicochemical properties, antioxidant and antimicrobial activity of okara soluble dietary fiber/sodium carboxymethyl cellulose/thyme essential oil active edible composite films incorporated with pectin. Int. J. Biol. Macromol. 2020, 165, 1241–1249. [Google Scholar] [CrossRef] [PubMed]
- Yeddes, W.; Djebali, K.; Wannes, W.A.; Horchani-Naifer, K.; Hammami, M.; Younes, I.; Tounsi, M.S. Gelatin-chitosan-pectin films incorporated with rosemary essential oil: Optimized formulation using mixture design and response surface methodology. Int. J. Biol. Macromol. 2020, 154, 92–103. [Google Scholar] [CrossRef] [PubMed]
- Dranca, F.; Talón, E.; Vargas, M.; Oroian, M. Microwave vs. conventional extraction of pectin from Malus domestica ‘Fălticeni’ pomace and its potential use in hydrocolloid-based films. Food Hydrocoll. 2021, 121, 107026. [Google Scholar] [CrossRef]
- Chen, S.; Xiao, L.; Li, S.; Meng, T.; Wang, L.; Zhang, W. The effect of sonication-synergistic natural deep eutectic solvents on extraction yield, structural and physicochemical properties of pectins extracted from mango peels. Ultrason. Sonochem. 2022, 86, 106045. [Google Scholar] [CrossRef]
- Wu, J.; Chen, S.; Ge, S.; Miao, J.; Li, J.; Zhang, Q. Preparation, properties and antioxidant activity of an active film from silver carp (Hypophthalmichthys molitrix) skin gelatin incorporated with green tea extract. Food Hydrocoll. 2013, 32, 42–51. [Google Scholar] [CrossRef]
- Siripatrawan, U.; Noipha, S. Active film from chitosan incorporating green tea extract for shelf life extension of pork sausages. Food Hydrocoll. 2012, 27, 102–108. [Google Scholar] [CrossRef]
- Siripatrawan, U.; Harte, B.R. Physical properties and antioxidant activity of an active film from chitosan incorporated with green tea extract. Food Hydrocoll. 2010, 24, 770–775. [Google Scholar] [CrossRef]
- Azizi-Lalabadi, M.; Rafiei, L.; Divband, B.; Ehsani, A. Active packaging for Salmon stored at refrigerator with Polypropylene nanocomposites containing 4A zeolite, ZnO nanoparticles, and green tea extract. Food Sci. Nutr. 2020, 8, 6445–6456. [Google Scholar] [CrossRef]
- Giménez, B.; de Lacey, A.L.; Pérez-Santín, E.; López-Caballero, M.; Montero, P. Release of active compounds from agar and agar–gelatin films with green tea extract. Food Hydrocoll. 2013, 30, 264–271. [Google Scholar] [CrossRef]
- Maroufi, L.Y.; Ghorbani, M.; Tabibiazar, M. A Gelatin-Based Film Reinforced by Covalent Interaction with Oxidized Guar Gum Containing Green Tea Extract as an Active Food Packaging System. Food Bioprocess Technol. 2020, 13, 1633–1644. [Google Scholar] [CrossRef]
- Munir, S.; Javed, M.; Hu, Y.; Liu, Y.; Xiong, S. The Effect of Acidic and Alkaline pH on the Physico-Mechanical Properties of Surimi-Based Edible Films Incorporated with Green Tea Extract. Polymers 2020, 12, 2281. [Google Scholar] [CrossRef] [PubMed]
- Panrong, T.; Karbowiak, T.; Harnkarnsujarit, N. Thermoplastic starch and green tea blends with LLDPE films for active packaging of meat and oil-based products. Food Packag. Shelf Life 2019, 21, 100331. [Google Scholar] [CrossRef]
- Wen, H.; Hsu, Y.-I.; Asoh, T.-A.; Uyama, H. Antioxidant activity and physical properties of pH-sensitive biocomposite using poly (vinyl alcohol) incorporated with green tea extract. Polym. Degrad. Stab. 2020, 178, 109215. [Google Scholar] [CrossRef]
- Setyawan, E.I.; Setyowati, E.P.; Rohman, A.; Nugroho, A.K. Central composite design for optimizing extraction of EGCG from green tea leaf (camellia sinensis L.). Int. J. Appl. Pharm. 2018, 10, 211–216. [Google Scholar] [CrossRef]
- Kaewprachu, P.; Osako, K.; Rungraeng, N.; Rawdkuen, S. Characterization of fish myofibrillar protein film incorporated with catechin-Kradon extract. Int. J. Biol. Macromol. 2018, 107, 1463–1473. [Google Scholar] [CrossRef]
- AOAC. Official Methods of Analysis of AOAC International, 17th ed.; Association of analytical communities: Gai-thersburg, MD, USA, 2000. [Google Scholar]
- ASTM. Standard test methods for water vapor transmission of materials. Standard designation E96–E80. In Annual Book of ASTM Standards; ASTM International: West Conshohocken, PA, USA, 1989; pp. 730–739. [Google Scholar]
- Mangmee, K.; Homthawornchoo, W. Antioxidant activity and physicochemical properties of rice starch-chitosan-based films containing green tea extract. Food Appl. Biosci. J. 2016, 4, 126–137. [Google Scholar]
- Tongnuanchan, P.; Benjakul, S.; Prodpran, T. Properties and antioxidant activity of fish skin gelatin film incorporated with citrus essential oils. Food Chem. 2012, 134, 1571–1579. [Google Scholar] [CrossRef]
- Benzie, I.F.F.; Strain, J.J. The ferric reducing ability of plasma (FRAP) as a measure of “antioxidant power”: The FRAP assay. Anal. Biochem. 1996, 239, 70–76. [Google Scholar] [CrossRef] [Green Version]
- Li, X.; Jin, J.; Sun, C.; Ye, D.; Liu, Y. Simultaneous determination of six main types of lipid-soluble pigments in green tea by visible and near-infrared spectroscopy. Food Chem. 2019, 270, 236–242. [Google Scholar] [CrossRef] [PubMed]
- Hopkins, E.J.; Chang, C.; Lam, R.S.; Nickerson, M.T. Effects of flaxseed oil concentration on the performance of a soy protein isolate-based emulsion-type film. Food Res. Int. 2015, 67, 418–425. [Google Scholar] [CrossRef]
- Lee, C.H.; An, D.S.; Lee, S.C.; Park, H.J.; Lee, D.S. A coating for use as an antimicrobial and antioxidative packaging material incorporating nisin and α-tocopherol. J. Food Eng. 2004, 62, 323–329. [Google Scholar] [CrossRef]
- Zhu, F. Interactions between starch and phenolic compound. Trends Food Sci. Technol. 2015, 43, 129–143. [Google Scholar] [CrossRef]
- Zhang, Y.; Li, S.; Yang, Y.; Wang, C.; Zhang, T. Formation and characterization of noncovalent ternary complexes based on whey protein concentrate, high methoxyl pectin, and phenolic acid. J. Dairy Sci. 2022, 105, 2963–2977. [Google Scholar] [CrossRef]
- Adilah, A.N.; Jamilah, B.; Noranizan, M.; Hanani, Z.N. Utilization of mango peel extracts on the biodegradable films for active packaging. Food Packag. Shelf Life 2018, 16, 1–7. [Google Scholar] [CrossRef]
- Detduangchan, N.; Sridach, W.; Wittaya, T. Enhancement of the properties of biodegradable rice starch films by using chemical crosslinking agents. Int. Food Res. J. 2014, 21, 1225–1235. [Google Scholar]
- Qin, Y.; Liu, Y.; Yuan, L.; Yong, H.; Liu, J. Preparation and characterization of antioxidant, antimicrobial and pH-sensitive films based on chitosan, silver nanoparticles and purple corn extract. Food Hydrocoll. 2019, 96, 102–111. [Google Scholar] [CrossRef]
- Obiro, W.C.; Ray, S.S.; Emmambux, M.N. V-amylose Structural Characteristics, Methods of Preparation, Significance, and Potential Applications. Food Rev. Int. 2012, 28, 412–438. [Google Scholar] [CrossRef] [Green Version]
- Ashwar, B.A.; Shah, A.; Gani, A.; Shah, U.; Gani, A.; Wani, I.A.; Wani, S.M.; Masoodi, F.A. Rice starch active packaging films loaded with antioxidants-development and characterization. Starch-Stärke 2015, 67, 294–302. [Google Scholar] [CrossRef]
- Bonilla, J.; Talón, E.; Atarés, L.; Vargas, M.; Chiralt, A. Effect of the incorporation of antioxidants on physicochemical and antioxidant properties of wheat starch–chitosan films. J. Food Eng. 2013, 118, 271–278. [Google Scholar] [CrossRef]
- Bertuzzi, M.A.; Castro Vidaurre, E.F.; Armada, M.; Gottifredi, J.C. Water vapor permeability of edible starch based films. J. Food Eng. 2007, 80, 972–978. [Google Scholar] [CrossRef]
- Xu, Y.; Kim, K.M.; Hanna, M.A.; Nag, D. Chitosan–starch composite film: Preparation and characterization. Ind. Crops Prod. 2005, 21, 185–192. [Google Scholar] [CrossRef]
- He, H.; Bian, H.; Xie, F.; Chen, L. Different effects of pectin and κ-carrageenan on the multiscale structures and in vitro digestibility of extruded rice starch. Food Hydrocoll. 2021, 111, 106216. [Google Scholar] [CrossRef]
- Lin, D.; Ma, Y.; Qin, W.; Loy, D.A.; Chen, H.; Zhang, Q. The structure, properties and potential probiotic properties of starch-pectin blend: A review. Food Hydrocoll. 2022, 129, 107644. [Google Scholar] [CrossRef]
- Ju, A.; Song, K.B. Development of teff starch films containing camu-camu (Myrciaria dubia Mc. Vaugh) extract as an antioxidant packaging material. Ind. Crops Prod. 2019, 141, 111737. [Google Scholar] [CrossRef]
- Piñeros-Hernandez, D.; Medina-Jaramillo, C.; López-Córdoba, A.; Goyanes, S. Edible cassava starch films carrying rosemary antioxidant extracts for potential use as active food packaging. Food Hydrocoll. 2017, 63, 488–495. [Google Scholar] [CrossRef]
- Rodrigues, R.; Patil, S.; Dhakane-Lad, J.; Nadanathangam, V.; Mahapatra, A. Effect of green tea extract, ginger essential oil and nanofibrillated cellulose reinforcements in starch films on the keeping quality of strawberries. J. Food Processing Preserv. 2022, 46, e16109. [Google Scholar] [CrossRef]
- Aminzare, M.; Hashemi, M.; Hassanzadazar, H.; Amiri, E.; Abbasi, Z. Antibacterial Activity of Corn Starch Films Incorporated with Zataria multiflora and Bonium persicum Essential Oils. Annu. Res. Rev. Biol. 2017, 19, 1–9. [Google Scholar] [CrossRef]
- Roy, S.; Rhim, J.-W. Preparation of antimicrobial and antioxidant gelatin/curcumin composite films for active food packaging application. Colloids Surf. B Biointerfaces 2020, 188, 110761. [Google Scholar] [CrossRef]
- Taylor, P.W.; Hamilton-Miller, J.M.; Stapleton, P.D. Antimicrobial properties of green tea catechins. Food Sci. Technol. Bull. 2005, 2, 71–81. [Google Scholar] [CrossRef] [PubMed] [Green Version]

| GTE (% w/v) | L* | a* | b* | ΔE* |
|---|---|---|---|---|
| 0.000 | 90.62 ± 0.84 a | −1.13 ± 0.04 c | 4.39 ± 0.03 e | 5.63 ± 0.62 e |
| 0.125 | 88.80 ± 0.52 b | −1.15 ± 0.02 c | 7.34 ± 0.31 d | 9.03 ± 0.37 d |
| 0.250 | 87.82 ± 0.60 c | −1.13 ± 0.05 c | 10.44 ± 0.65 c | 12.11 ± 0.73 c |
| 0.500 | 86.91 ± 0.72 d | −1.04 ± 0.04 b | 14.61 ± 0.69 b | 16.16 ± 0.83 b |
| 1.000 | 84.57 ± 0.57 e | −0.52 ± 0.17 a | 24.48 ± 1.26 a | 26.11 ± 1.32 a |
| GTE (% w/v) | Transmittance (%T) at Wavelength (nm) | Transparency * | |||||||
|---|---|---|---|---|---|---|---|---|---|
| 200 | 280 | 350 | 400 | 500 | 600 | 700 | 800 | ||
| 0.000 | 0.10 | 42.50 | 71.66 | 78.71 | 84.72 | 87.28 | 88.60 | 89.33 | 3.29 ± 0.003 a |
| 0.125 | 0.04 | 1.06 | 37.48 | 64.37 | 75.55 | 79.34 | 81.22 | 82.56 | 3.21 ± 0.005 b |
| 0.250 | 0.04 | 0.03 | 19.32 | 56.08 | 74.07 | 78.95 | 81.12 | 82.49 | 3.17 ± 0.007 c |
| 0.500 | 0.03 | 0.01 | 8.71 | 46.26 | 71.47 | 77.50 | 79.82 | 81.23 | 3.15 ± 0.004 d |
| 1.000 | 0.02 | 0.01 | 0.79 | 25.14 | 65.71 | 75.63 | 78.52 | 80.66 | 3.09 ± 0.029 e |
| GTE (%, w/v) | Thickness (mm) | TS (MPa) | EAB (%) | MC (%) | FS (%) | WVP (×10–11 g m/m2 s Pa) |
|---|---|---|---|---|---|---|
| 0.000 | 0.045 ± 0.001 d | 4.40 ± 0.12 a | 24.57 ± 1.57 a | 30.38 ± 0.36 a | 45.46 ± 4.15 a | 10.02 ± 0.41 a |
| 0.125 | 0.049 ± 0.001 c | 3.53 ± 0.26 b | 24.12 ± 1.89 a | 28.58 ± 0.56 ab | 46.43 ± 5.80 a | 9.57 ± 1.13 ab |
| 0.250 | 0.053 ± 0.001 b | 2.49 ± 0.26 c | 21.35 ± 3.07 b | 27.05 ± 0.69 bc | 47.13 ± 0.83 a | 9.09 ± 0.32 ab |
| 0.500 | 0.055 ± 0.001 b | 2.41 ± 0.09 c | 19.15 ± 1.52 bc | 25.58 ± 0.44 cd | 50.42 ± 6.30 a | 8.38 ± 1.59 ab |
| 1.000 | 0.061 ± 0.003 a | 2.12 ± 0.12 d | 18.53 ± 2.54 c | 23.57 ± 2.77 d | 52.52 ± 4.95 a | 7.94 ± 0.13 b |
Publisher’s Note: MDPI stays neutral with regard to jurisdictional claims in published maps and institutional affiliations. |
© 2022 by the authors. Licensee MDPI, Basel, Switzerland. This article is an open access article distributed under the terms and conditions of the Creative Commons Attribution (CC BY) license (https://creativecommons.org/licenses/by/4.0/).
Share and Cite
Homthawornchoo, W.; Han, J.; Kaewprachu, P.; Romruen, O.; Rawdkuen, S. Green Tea Extract Enrichment: Mechanical and Physicochemical Properties Improvement of Rice Starch-Pectin Composite Film. Polymers 2022, 14, 2696. https://doi.org/10.3390/polym14132696
Homthawornchoo W, Han J, Kaewprachu P, Romruen O, Rawdkuen S. Green Tea Extract Enrichment: Mechanical and Physicochemical Properties Improvement of Rice Starch-Pectin Composite Film. Polymers. 2022; 14(13):2696. https://doi.org/10.3390/polym14132696
Chicago/Turabian StyleHomthawornchoo, Wantida, Jaejoon Han, Pimonpan Kaewprachu, Orapan Romruen, and Saroat Rawdkuen. 2022. "Green Tea Extract Enrichment: Mechanical and Physicochemical Properties Improvement of Rice Starch-Pectin Composite Film" Polymers 14, no. 13: 2696. https://doi.org/10.3390/polym14132696
APA StyleHomthawornchoo, W., Han, J., Kaewprachu, P., Romruen, O., & Rawdkuen, S. (2022). Green Tea Extract Enrichment: Mechanical and Physicochemical Properties Improvement of Rice Starch-Pectin Composite Film. Polymers, 14(13), 2696. https://doi.org/10.3390/polym14132696

